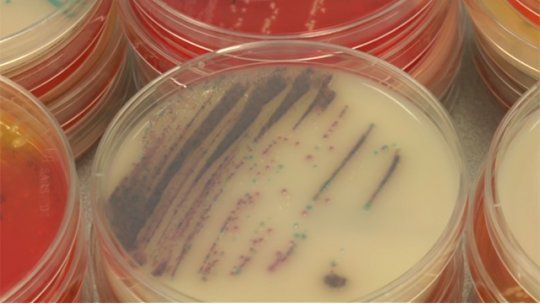
botulismo

El Ministerio de Salud Pública (MSP) espera los resultados de muestras de sangre extraídas a una mujer de 35 años que falleció en una mutualista de Rivera.
Salud Pública analiza muerte por posible caso de botulismo en Rivera
Se trata de una mujer de 35 años que falleció en una mutualista. El diagnóstico deberá ser confirmado por análisis enviados a Argentina.
Se sospecha de un posible caso de botulismo, una enfermedad que se trasmite a través de los alimentos contaminados, sobre todo de los enlatados en mal estado o vencidos.
“Empíricamente hay un diagnóstico sugestivo de que puede ser un caso probable de botulismo”, dijo la subsecretaria de Salud Pública, Cristina Lustemberg.
"Así te estés muriendo, tampoco hay hora" y "no he tenido problema": usuarios opinan sobre tiempos de espera en la salud
La autoridad sanitaria está a la espera de los resultados de los análisis de sangre y materia que fueron enviados a Argentina.
“Esta es una enfermedad inusual, pero potencialmente grave”, destacó Lustemberg.
Las toxinas que trasmite el botulismo afectan el sistema nervioso y provoca una parálisis progresiva que puede producir insuficiencia respiratoria.
Los síntomas iniciales incluyen fatiga intensa, debilidad y vértigo, seguidos generalmente por visión borrosa, sequedad de boca y dificultad para tragar y hablar.
Lo más visto
video
Dejá tu comentario